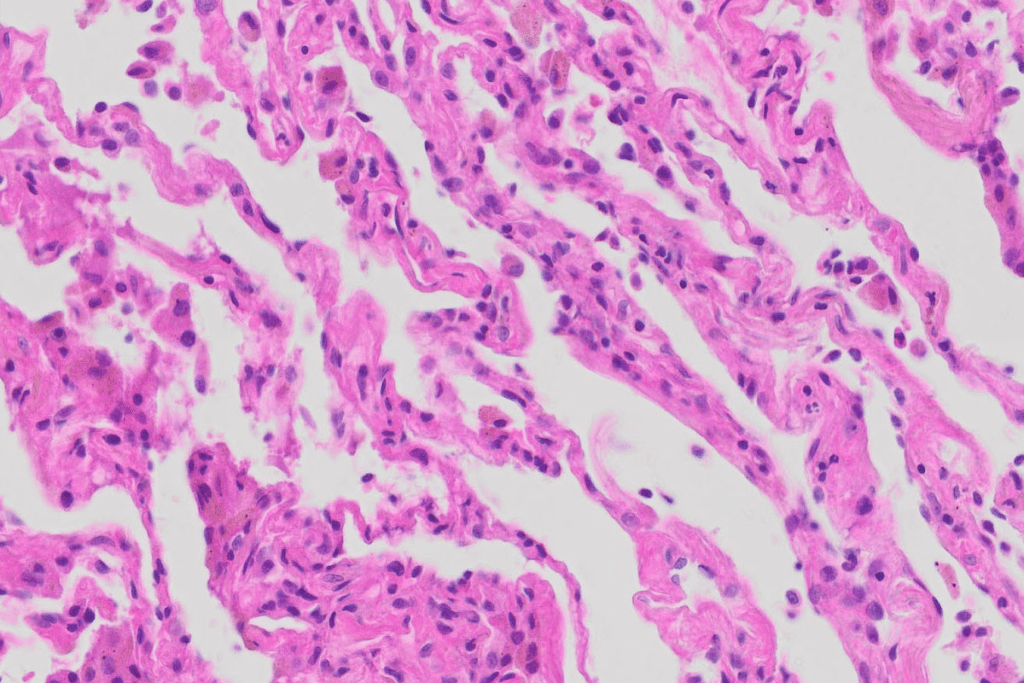
PET Scan Lungs: Powerful Imaging for Lung Disease Detection 3 PET Scan Lungs: Powerful Imaging for Lung Disease Detection

Last Updated on December 1, 2025 by Bilal Hasdemir

Lung cancer is a major cause of death worldwide. Early detection is key for effective treatment. The Positron Emission Tomography (PET) scan of the lungs has changed how we detect and manage lung conditions.
A PET scan of the lungs is a non-invasive test. It shows the metabolic activity of lung tissues. A small amount of radioactive material, usually FDG (fluorodeoxyglucose), is injected into the bloodstream. It goes to areas with high activity, like cancer cells.
The lung PET scan is great for finding and checking lung cancer. It also helps see how well treatments are working. It gives detailed images of the lungs, helping doctors make better decisions for patients.
Key Takeaways
- A PET scan of the lungs is a non-invasive diagnostic test.
- It helps diagnose and monitor lung conditions by visualizing metabolic activity.
- FDG is commonly used as the radioactive tracer.
- It’s useful for detecting and staging lung cancer.
- Evaluating pulmonary nodules and monitoring treatment effectiveness are other key uses.
The Fundamentals of PET Scan Lungs

PET scan lungs use radioactive tracers to find lung function problems. This tech is key in diagnosing and treating lung diseases.
The Science Behind Positron Emission Tomography
PET scans use radioactive tracers to see how lung tissues work. The main tracer is FDG (Fluorodeoxyglucose). It goes to areas that use a lot of sugar, like cancer cells.
The PET scanner finds this radiation. It makes detailed pictures of the lungs.
Metabolic Activity Detection in Lung Tissue
PET scans can spot metabolic activity in lung tissue. This helps find tumors or inflammation early. It’s great for lung cancer detection and treatment tracking.
| Characteristics | PET Scan | Other Imaging Techniques |
| Metabolic Activity Detection | High sensitivity for detecting metabolic changes | Limited to structural information |
| Use of Radioactive Tracers | Utilizes tracers like FDG to highlight areas of high glucose metabolism | Does not use radioactive tracers |
| Clinical Applications | Effective in cancer diagnosis, staging, and treatment monitoring | Varied applications, including structural assessment |
Understanding lung tissue metabolism helps doctors make better decisions. PET scan technology has greatly improved lung disease diagnosis and treatment.
Radioactive Tracers in Lung PET Imaging
Radioactive tracers are key in PET scans for finding lung tumors. These tracers give off positrons. When these positrons meet electrons, they create gamma rays that PET scanners can detect.
FDG: The Primary Tracer for Metabolic Lung Scans
FDG (fluorodeoxyglucose) is the top choice for PET scans in lung cancer. It goes to areas with lots of glucose, like cancer cells. This helps doctors spot tumors and check if treatments are working.
FDG has changed how we fight cancer, making lung cancer management better.
How Tracers Highlight Abnormal Cellular Activity
The tracer is first injected into the blood. It then goes to areas with lots of activity. Cancer cells, with their high metabolism, grab more of it.
During the scan, these active areas show up as “hot spots.” This means they could be tumors or other issues. This info is key for diagnosing, understanding the disease’s stage, and seeing how treatments are doing.
With tracers like FDG, PET scans give deep insights into lung tissue activity. This helps doctors make better choices for their patients.
Clinical Applications of PET Scans for Lungs
PET scans are key in diagnosing and managing lung diseases. They have many uses that are vital for patient care.
Lung Cancer Detection and Staging
Lung cancer pet scans are vital for finding and staging lung cancer. They show how active tumors are, which helps figure out how far the disease has spread.
Using PET scans for lung cancer staging has made treatment planning better. It helps doctors know how to target treatments based on the cancer’s stage.
Evaluating Pulmonary Nodules
PET scans check pulmonary nodules, which could be harmless or cancerous. The pet scan for lung nodules shows how active they are, helping doctors decide what to do next.
This is very helpful for finding nodules that might be cancerous and need more tests or biopsies.
Identifying Lung Metastases from Other Primary Cancers
PET scans can spot lung metastases from other cancers. This is important for figuring out how far the cancer has spread and what treatment to use.
The pet scan lung metastases feature helps doctors see how much cancer is there and if treatments are working.
Here is a summary of the clinical applications of PET scans for lungs:
| Clinical Application | Description | Benefit |
| Lung Cancer Detection and Staging | Identifies metabolic activity of tumors | Improves treatment planning and prognosis |
| Evaluating Pulmonary Nodules | Determines metabolic activity of nodules | Aids in diagnosis and identifies potentially malignant nodules |
| Identifying Lung Metastases | Detects metastases from other primary cancers | Assesses extent of disease and monitors treatment effectiveness |
PET scans give vital information for lung health management. Knowing how PET scans work helps doctors make better decisions for patient care.
PET-CT Chest Scans: Combined Imaging Advantage
PET and CT imaging together in chest scans help doctors understand lung diseases better. They combine PET’s functional info with CT’s detailed images. This makes PET-CT chest scans a strong tool for diagnosis.
Integration of Anatomical and Functional Information
PET-CT scans use the best of both worlds, showing a full view of lung health. They pinpoint where lung problems are, making diagnoses more accurate.
The benefits of this combined method are:
- Enhanced detection of lung abnormalities
- Improved staging of lung cancer
- Better assessment of treatment response
- More accurate characterization of pulmonary nodules
PET-CT Advantages in Lung Assessment
PET-CT scans have many benefits for lung assessment. They give both functional and anatomical details. This helps doctors make better choices for patient care.
Key advantages include:
- Improved diagnostic confidence
- Enhanced detection of metastatic disease
- Guidance for biopsy and treatment planning
In conclusion, PET-CT chest scans are a big step forward in lung disease diagnosis and treatment. They offer a detailed and accurate view that helps doctors make the right decisions.
The Complete Lung PET Scan Procedure
The lung PET scan procedure has several key steps. These steps help get accurate results. They show how well the lungs work and their metabolism, helping diagnose and manage lung diseases.
Pre-Scan Preparation and Assessment
Before a lung PET scan, patients must prepare. They need to faste for several hours before the scan. This ensures the scan images are clear, not affected by food.
They should also avoid strenuous exercise before the scan. This helps prevent changes that could affect the scan results.
Healthcare providers will look at the patient’s medical history during the pre-scan assessment. They check for any existing conditions and current medications. This step is important to make sure the PET scan is right for the patient and to spot any risks.
Radioactive Tracer Administration
Administering a radioactive tracer is a key part of the PET scan. The most used tracer is FDG (fluorodeoxyglucose). It goes to areas with high activity, like tumors.
The tracer is injected into the blood. Then, the patient waits a bit for it to spread throughout the body.
The Scanning Process and Duration
After the tracer is given and has circulated, the patient lies on a scanning table. The table moves into the PET scanner. The scanning process involves staying very quiet while the scanner takes images of the lungs.
The scan usually lasts 30 to 60 minutes. During this time, the PET scanner picks up signals from the tracer. It uses these signals to make detailed images of the lungs. These images show how well the lungs are working and help doctors diagnose and treat lung diseases.
Preparing for Your Lung PET Scan
Learning how to prepare for a lung PET scan can make you feel less anxious. It’s important to prepare well to get accurate results from your scan.
Dietary Restrictions and Fasting Requirements
Following dietary restrictions is a big part of preparing for a PET scan. You’ll likely need to fast for 4 to 6 hours before the scan. It’s best to avoid sugary foods and drinks for 24 hours before.
Drinking water is encouraged to stay hydrated. Also, don’t have caffeine or certain medications that could mess with the scan. Your doctor will tell you what to do based on your situation.
Medication Considerations Before Imaging
Tell your doctor about all the medications you’re taking before the scan. Some might need to be stopped or changed to avoid affecting the scan.
Your doctor will tell you if you need to stop any medications and for how long. It’s important to follow these instructions to get the best scan results.
What to Wear and Bring to Your Appointment
Wear comfy clothes that let you move easily on the day of your scan. Avoid jewelry or metal items as they can cause problems. Leave metal items at home to avoid delays.
Bring any medical records, a list of your medications, and other documents your doctor might ask for. Arriving a bit early will help you finish any paperwork needed.
Interpreting PET Scan Results for Lung Abnormalities
PET scan results give us important clues about lung health. They show where the body is working hard, which is key for spotting lung problems like cancer.
Understanding SUV Values and “Hot Spots”
The Standardized Uptake Value (SUV) is a key part of PET scans. It shows how active a spot is, with higher values meaning it might be more serious. “Hot spots” are areas that are very active, which could mean cancer.
When looking at SUV values, doctors consider a few things. They look at the size of the spot and the patient’s health. A high SUV value often means the disease might be more aggressive. But, other things like inflammation can also raise SUV values.
How Radiologists Read Lung PET Results
Radiologists are key in understanding PET scan results. They look at the images to find spots that are not working right. They also think about the patient’s health and other tests.
They check the PET scan images for “hot spots” and their SUV values. They also compare these results with other tests, like CT scans. This helps them understand lung problems better.
By using PET scan results with other information, radiologists can make accurate diagnoses. They help decide the best treatment for lung issues.
PET Scan for Lung Nodules: Diagnostic Value
PET scans are very important for checking lung nodules. They help tell if a growth is harmless or cancerous. This is key for solitary pulmonary nodules (SPNs), which are unusual lung growths found by imaging tests.
Evaluating Solitary Pulmonary Nodules
Solitary pulmonary nodules are often seen on chest CT scans. Knowing if they are harmful is very important. PET scans use fluorodeoxyglucose (FDG), a radioactive tracer, to find cancerous growths.
They do this by looking at how much FDG the nodule takes in. This helps spot likely cancerous nodules.
Differentiating Benign vs. Malignant Characteristics
PET scans can tell if a lung nodule is cancer or not. This is because cancer grows faster and uses more energy. So, it takes in more FDG than harmless nodules.
This info is key for deciding what to do next. It might mean more tests, a biopsy, or starting treatment.
| Nodule Characteristics | PET Scan Findings | Clinical Implication |
| High Metabolic Activity | High FDG Uptake | Likely Malignant |
| Low Metabolic Activity | Low FDG Uptake | Likely Benign |
In summary, PET scans are very important for lung nodule checks. They give vital info for diagnosis and treatment plans. This helps doctors make better choices for patient care.
PET Scan vs CT Lungs: Comparative Analysis
PET scans and CT scans are both used to look at the lungs. They give different kinds of information. Knowing what each scan does helps doctors pick the right one for each patient.
Structural vs. Functional Information
PET scans show how active lung tissues are. This is key for finding cancer or other problems. CT scans, on the other hand, show the lung’s shape and structure. They help spot things like tumors or changes in the lungs.
Choosing between PET and CT scans depends on what the doctor needs to know. For example, PET scans are better for checking on tumors. CT scans are better for looking at lung details.
When Each Imaging Method is Preferred
PET scans are great for cancer staging and checking how treatments work. They’re also good for some infections. CT scans are better for detailed lung views and for guiding biopsies. They help spot things like blood clots or infections.
Using both PET and CT scans together (PET-CT) is often the best choice. It gives doctors both the activity and structure of the lungs at once. This helps make a more complete treatment plan.
Lung Cancer Staging Using PET Imaging
PET imaging greatly improves lung cancer staging. It gives detailed insights into how far the disease has spread. PET scans are key in showing how cancer has spread within the lungs and to other parts of the body.
TNM Classification Enhancement with PET Data
The TNM system is a common way to stage lung cancer. PET data adds valuable metabolic information about tumors. The TNM system looks at three main factors:
- T (Tumor): The size and extent of the main tumor.
- N (Node): The degree to which nearby lymph nodes are affected.
- M (Metastasis): Whether the cancer has spread to other parts of the body.
PET scans help accurately assess these factors. They are key in spotting metastatic disease that other scans might miss.
Impact on Treatment Planning and Prognosis
PET scan data greatly affects treatment planning and prognosis. It helps doctors:
- Choose the best treatment, like surgery, chemotherapy, or radiation.
- Make more accurate predictions about patient outcomes. This helps in deciding on treatment intensity.
A study in a medical journal highlights PET-CT’s role in lung cancer staging. It shows how it influences treatment choices and can improve patient outcomes.
“The integration of PET imaging into the staging process for lung cancer represents a significant advancement in the management of this disease.”
Limitations in Certain Lung Cancer Types
PET imaging is very useful in lung cancer staging, but it has its limits. Some tumors are hard to spot because they don’t show up well on PET scans.
It’s important to know these limits. This helps in understanding PET scan results and choosing the right imaging for each patient.
PET Scans for Non-Cancerous Lung Conditions
PET scans are key in checking non-cancer lung issues. They show how lung tissues work, helping doctors spot and treat many lung problems.
Detecting Lung Inflammation and Infection
PET scans are great at finding lung inflammation and infections. The FDG PET scan spots where sugar levels are high, which means inflammation. This is key for finding pneumonia or abscesses and treating them right.
These scans are super helpful for patients with tough lung infections, like those with weak immune systems. They show where the disease is active, helping doctors plan the best treatment for each patient.
Evaluating Interstitial Lung Diseases
ILDs are a bunch of lung diseases with inflammation and scarring. PET scans help see how bad these diseases are and how they’re changing.
Using PET scans in ILDs helps find where the inflammation is, even if regular scans can’t. This info is key for deciding on treatments, like medicines to calm the immune system.
| Condition | PET Scan Findings | Clinical Implication |
| Lung Inflammation | Increased FDG uptake in affected areas | Guides anti-inflammatory treatment |
| Lung Infection | Localized areas of increased metabolism | Directs antibiotic or antifungal therapy |
| Interstitial Lung Disease | Variable uptake patterns indicating disease activity | Informs treatment decisions and prognosis |
PET scans give doctors a lot of useful info for non-cancer lung issues. They show how active and widespread the disease is. This helps doctors make better choices for their patients.
Safety Considerations in Lung PET Scan Procedures
It’s important to know about the safety of PET scans for lung checks. These scans use small amounts of radiation. We need to think about the risks and benefits.
Radiation Exposure Levels
PET scans are generally safe, but they do involve some radiation. The dose is usually between 4 to 7 millisieverts (mSv). This is similar to a chest CT scan’s dose. But, the exact risk is a topic of ongoing debate.
Several factors affect how much radiation you get:
- The type and amount of radioactive tracer used
- Your body size and what you’re made of
- The scanning method and technology used
Risk-Benefit Analysis for Different Patient Groups
When we talk about PET scans, we must weigh their benefits against the risks. This is very important for certain groups, like kids and pregnant women.
For children: PET scans are used less because kids are more sensitive to radiation. But, when they are needed, the dose is kept as low as possible.
For pregnant women: PET scans are usually avoided because of the risk to the unborn baby. If a scan is needed, the dose is carefully managed, and the risks are explained to the patient.
Deciding to have a PET scan should be a careful choice. It’s best to talk it over with your doctor. They can help you understand the scan’s benefits based on your situation.
Advantages and Limitations of Lung PET Imaging
PET scans for lung conditions have big benefits and some downsides. They are key in diagnosing and managing lung diseases, like cancer.
Clinical Benefits of Functional Lung Assessment
PET scans show how active lung tissue is, which regular images can’t. This is vital for spotting problems early, like cancer.
Key benefits of PET scans for lung assessment include:
- Early detection of lung cancer
- Accurate staging of lung cancer
- Monitoring response to treatment
- Identifying metabolically active tissues
Experts say PET/CT is vital for lung cancer management. It gives both structure and function info.
This mix of data boosts accuracy and helps plan treatments.
Understanding False Positives and False Negatives
PET scans are very sensitive but not flawless. False positives can cause worry and more tests. False negatives might miss small tumors or low activity.
| Condition | PET Scan Result | Implication |
| Inflammation | False Positive | Unnecessary concern and additional testing |
| Small Tumor | False Negative | Disease progression if not detected early |
It’s key to know these limits to understand PET scan results. Doctors should look at the whole picture and use other tests too.
In summary, PET scans are great for lung imaging, showing function and catching diseases early. But, they have limits. By using PET scans with other info and tests, doctors can give better care.
Conclusion: The Evolving Role of PET Scans in Pulmonary Medicine
PET scans are becoming key in diagnosing and treating lung diseases like cancer and interstitial lung disease. As technology improves, PET scans will play an even bigger role in detecting and treating lung conditions.
is now a vital tool for spotting lung problems early. Thanks to , doctors can get clearer pictures of lung issues. This helps them create better treatment plans.
The role of PET scans in lung care will keep growing as medicine advances. By knowing the strengths and weaknesses of , doctors can give better care. This will lead to better health outcomes for patients with lung diseases.
FAQ
What is a PET scan of the lungs, and how does it work?
A PET scan of the lungs is a test that uses a small amount of radioactive material. It shows how active lung tissues are. It works by finding the radiation from a tracer, like FDG, which goes to areas that are very active, like cancer cells.
What is FDG, and why is it used in PET scans for lung cancer?
FDG, or fluorodeoxyglucose, is a radioactive tracer used in PET scans for lung cancer. It goes to areas that use a lot of glucose, like cancer cells. This helps doctors find tumors and see if treatment is working.
How is a PET scan used in the diagnosis and management of lung conditions?
PET scans help find and check how far lung cancer has spread. They also help find lung nodules and spots from other cancers. Doctors use them to see how well treatment is working and if cancer comes back.
What is the difference between a PET scan and a CT scan of the lungs?
PET scans show how active lung tissues are, while CT scans show the lung’s structure. The choice depends on what the doctor needs to know.
How do I prepare for a PET scan of the lungs?
To get ready for a PET scan, you might need to fast for a few hours. You should avoid certain medicines and wear loose clothes. Don’t wear jewelry or metal things.
What are SUV values, and how are they used in interpreting PET scan results?
SUV, or Standardized Uptake Value, shows how active a lesion is. Higher values mean more aggressive disease. Doctors use SUV values to find and check “hot spots” on PET scans.
Can PET scans be used to detect lung inflammation and infection?
Yes, PET scans can spot lung inflammation and infection. They also help with interstitial lung diseases. The scan shows how far the disease has spread and if treatment is working.
Are PET scans safe, and what are the risks associated with radiation exposure?
PET scans use a small amount of radiation. The risks and benefits need to be thought about carefully. The radiation levels are usually safe, but the risks and benefits vary for different people, like children and pregnant women.
References
- Environmental Radiology. (2025, April 22). How to prepare for PET scan.
- Brown University Health. (n.d.). How to prepare for your PET/CT sca





